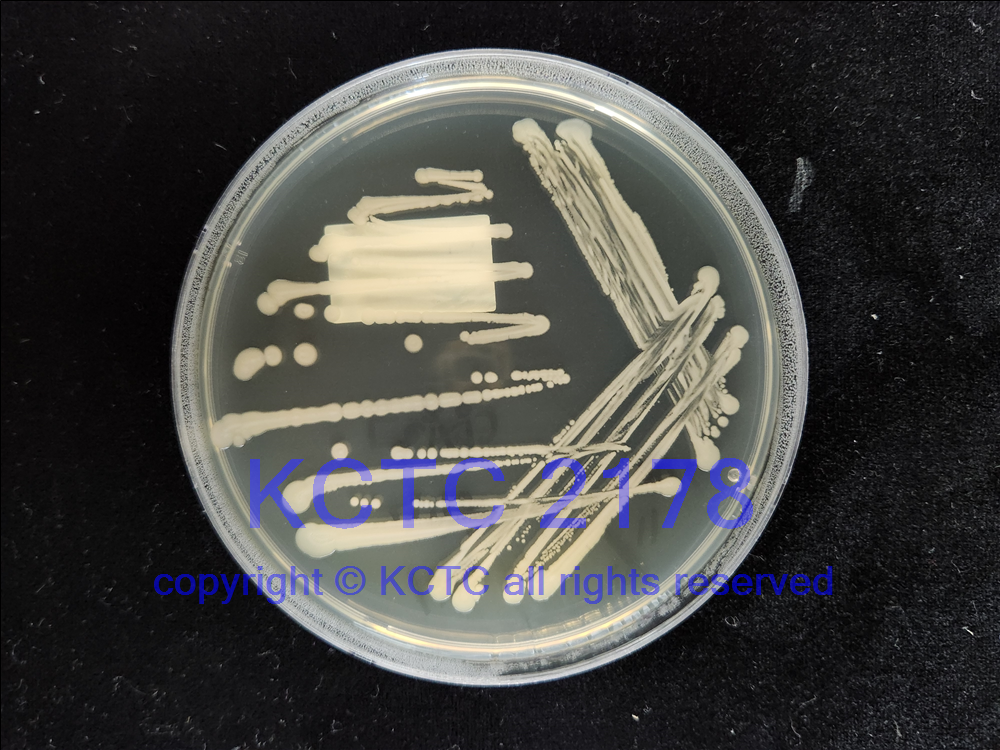

Priestia megaterium
DSM 509
BACTERIA
 How to read the following data (Example)
How to read the following data (Example)
Name:
Priestia megaterium(de Bary 1884) Gupta et al. 2020
DSM No.:
509
Other collection no.or WDCM no.:
CCM 1464,IFO 12109,NBRC 12109
Country:
country of origin unknown
Date of sampling:
before 22.08.1990
Nagoya Protocol Restrictions:
There are NO known Nagoya Protocol restrictions for this strain.
History:
<- H.J. Somerville <- NCIB <- NRRL
Cultivation conditions:
Medium 1, 30°CComplete DSMZ Media List
Summary andadditional information:
<- H.J. Somerville <- NCIB <- NRRL. Taxonomy/description (2413). Produces vitamin B12(= cyanocobalamine) (366). Nutrition (2422). (Medium 1, 30°C).
Literature:
366,2413,2422
Risk group:
1 (+) (classification according to GermanTRBA)
Supplied as:
Delivery formPricesFreeze Dried100,- €Active culture on request240,- €DNA150,- €Price Category for this culture:1Freight and handling charges will be added.See price list.Priestia megaterium
DSM 509 ATCC [10778], CCM [1464], DSM [509], IFO [12109], NCIMB [8508], NCIMB [8578], NRRL [B-938]
BACTERIA
 How to read the following data (Example)
How to read the following data (Example)Name:
Priestia megaterium(de Bary 1884) Gupta et al. 2020
DSM No.:
509
Other collection no.or WDCM no.:
CCM 1464,IFO 12109,NBRC 12109
Country:
country of origin unknown
Date of sampling:
before 22.08.1990
Nagoya Protocol Restrictions:
There are NO known Nagoya Protocol restrictions for this strain.
History:
<- H.J. Somerville <- NCIB <- NRRL
Cultivation conditions:
Medium 1, 30°CComplete DSMZ Media List
Summary andadditional information:
<- H.J. Somerville <- NCIB <- NRRL. Taxonomy/description (2413). Produces vitamin B12(= cyanocobalamine) (366). Nutrition (2422). (Medium 1, 30°C).
Literature:
366,2413,2422 KCTC 2178
Risk group:
1 (+) (classification according to GermanTRBA)
Supplied as:
Delivery formPricesFreeze Dried100,- €Active culture on request240,- €DNA150,- €Price Category for this culture:1Freight and handling charges will be added.See price list.
DSM509